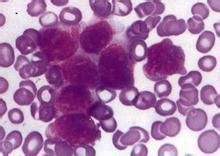
白血病m3

基本內容
白血病患者要從白血病患者的生活、飲食、心理、化療、輸血、發熱及出血等方面進行護理。白血病已不再是必死的絕症,及時發現、正確治療,尤其是重視臨床中對患者的密切觀察和積級護理、預防併發症,可顯著提高白血病患者的生存率。
病發誘因
白血病m3有確實證據可以肯定各種電離輻射條件可以引起人類白血玻白血病的發生取決於人體吸收輻射的劑量,整個身體或部分軀體受到中等劑量或大劑量輻射後都可誘發白血玻然而,小劑量的輻射能否引起白血病,仍不確定。
二、化學因素:
一些化學物質有致白血病的作用。如接觸苯及其衍生物的人群白血病發生率高於一般人群。亞硝胺類物質,保泰松及其衍生物、氯黴素等誘發白血病的報告也可見到,但還缺乏統計資料。
三、病毒因素:
RNA腫瘤病毒在鼠、貓、雞和牛等動物的致白血病作用已經肯定,這類病毒所致的白血病多屬於T細胞型。
近年從成人T細胞白血病和淋巴瘤患者分離出人類T細胞白血病病毒(HTLV),它是一種C型逆轉錄病毒。
病發症狀
白血病絕大多數病人有發熱,表現為低熱或高熱,多數為反覆不規則熱型。大部分白血病病人雖然外周血中白細胞數量很多,但這些細胞大多沒有正常白細胞的抗感染的作用。
二、貧血
常為首發症狀,且進行性加重。主要表現為皮膚黏膜蒼白、頭暈、乏力、心悸、氣急及多汗。貧血的原因是因為異常白細胞的過度增殖,抑制了正常紅細胞的生成,而且生成的紅細胞的壽命比正常紅細胞短,即紅細胞的數量和質量都下降,所以病人常常表現為疾病越重,貧血的症狀也越重。
三、出血
出血的程度輕重不一。以皮膚、黏膜和鼻腔出血多見。皮膚和黏膜出血的特點是出現數量不等的紫紅色的瘀點或瘀斑,壓之不退色。如果沒有新的出血,這些瘀點和瘀斑約在一周內逐漸變淡消退,但病人常常表現為舊的出血點剛剛消失,新的出血點又由現,有新舊交替出現的特點。
四、白血病細胞的浸潤症狀
①肝、脾、淋巴結腫大。腫大的肝、脾質地中等偏硬,部分有壓痛。淋巴結腫大為全身性,但多以頸部、頜下和腹股溝等處為多見。
②骨關節疼痛。白血病細胞浸潤破壞骨皮質和骨膜時可引起疼痛。胸骨壓痛對疾病的診斷有重要意義。關節疼痛局部常無紅、腫、熱現象。
③白血病細胞對腦實質和腦膜浸潤引起神經系統症狀,包括頭痛、噁心、嘔吐、抽搐、偏癱、意識喪失等。
④睪丸、胃腸道、肺、皮膚、牙齦和口腔黏膜,由於白細胞浸潤引起相應的症狀。
治療方案
一、化療
白血病二、中西醫結合治療
中西醫結合治療,能取長補短,中醫中藥能彌補西醫化療不分敵我一味殺的不足,又能解決對化療藥耐藥的問題,同時一些低增生性白血病,本來白血胞、血小板很低,經不住強力的化療藥,可用中醫中藥來治療,既避免了西藥的毒副作用,又能緩解病情,中西醫結合治療有以下形式。
1.單純中醫中藥治療,適用於低增生性的白血病,不能耐受化療,可用中藥。再是患病之初始終未用化療藥,尚未產生耐藥性者,可用中醫中藥,中醫藥治療適於幼稚細胞不是很高的患者。
2.中西藥結合,即化療期後配合扶正中藥。以升提白細胞、血小板、增強人體的免疫機能及抗感染。止血的功能,在化療緩解期仍可使用中醫藥,一是促進人體的恢復,二是鞏固化療的效果,延緩下一次化療時間。
三、生物調節劑治療
隨著免疫學和基因技術的發展生物調節劑治療已被用於臨床,其中白介素Ⅱ、多種造血刺激因子如GM-CSF、G-CSF、M-GCSF紅細胞生成素,腫痛壞死因子,干擾素等,經臨床驗證,白介素Ⅱ,LAK細胞等對白血病有一定療效,G-CSF、GM-CSF等用於化療後骨髓抑制病人,可明顯縮短骨髓和血象的抑制,加速緩解並減少併發症的發生。
四、基因治療
基因治療就是向靶細胞(組織)導入外源基因,以糾正補償或抑制某些異常或缺陷基因,從而達到治療目的。其治療方式可分成四類:①基因補償:把有正常功能基因轉入靶細胞以補償缺失或失活。②基因糾正:消除原藥異常基因,以外源基因取代之。③基因代償:外源正常基因表達水平超過原藥的異常基因表達水平。④反義技術:用人工合成或生物體合成的特定互補的DNA或RNA片段或其化學修飾產物抑制或封閉異常或缺失的基因表達。
五、骨髓移植(BMT)
1.異基因骨髓移植(Allo-BMT),是對病人進行超大劑量放療,化療預處理後,將健康骨髓中的造血幹細胞植入病人體內,使其造血及免疫功能獲得重建的治療方法。
2.自體幹細胞移植和臍血造血幹細胞移植
所謂自體幹細胞移植是指在大劑量放化療前採集自體造血幹細胞,使之免受大劑量放化療之損傷,並在大劑量放化療後回輸,自體造血幹細胞可來源於骨髓,亦可採集於患者外周血。自體幹細胞移植由於無移植物抗宿主病等合併症,可用於年齡較大的患者。其步驟是將造血幹細胞採集後,在零上和零下溫度保存,然後解凍回輸,移植前首先需要進行自體幹細胞的純化和殘留白細胞的淨化。對患者進行必要的檢查和放化療預處理,移植後要予控制感染、出血等支持治療,自體幹細胞移植效果優於常規化療,有報告認為是急性白血病CR後有效的鞏固治療措施之一,其缺點是復發率高,對於其存活時間及原因尚無統一說法。
護理方法
白血病細胞由於化化療起病人抵抗力低下,因此化療期間須預防感染。保持病室整潔,每日用紫外線消毒室內空氣;減少探視,避免交叉感染的發生;定期洗澡換衣,保持皮膚清潔乾燥;預防口腔感染,每日用抗菌素漱口,如甲硝唑、慶大黴素等。如有黴菌感染,可加用制黴菌素;大便後用1:5000PP粉的溶液坐浴,或清洗外陰,防止肛周感染;女性病人月經期間應每日清洗會陰部;注射部需嚴格消毒。定時測量體溫、脈博、呼吸、血壓等,注意觀察有無皮膚損害、咽痛、咳嗽、發熱等現象以便及時通知醫師,作出處理。
2、由於白血病病情重,發展快,加上化療常可引起脫髮、麻木、乏力、發熱等併發症。病人容易產生悲觀沮喪的情緒,甚至對治療失去信心。醫護人員應關心體貼病人,在化療前應向病人講清可能引起的反應,並說明這些反應多是暫時性的,待停止用藥後多可恢復正常,鼓勵病人樹立戰勝疾病的信心,與醫護人員密切配合,渡過危險期。
3、化療藥物的觀察護理。化療藥物對血管刺激性大,套用化療藥須注意保護血管。靜注化療藥必須小心仔細,確知針頭在血管內時方可推藥,推藥速度要慢,以減輕對血管的刺激。要避免藥液外溢,否則易造成組織損傷壞死。一旦外溢,立即用利多卡因局部封閉,減輕局部損傷。注意觀察化療藥的毒副作用,如長春新鹼,可造成口唇、手、腳發麻等末梢神經炎表現。三尖杉酯鹼或柔紅黴素可致心臟毒性等。須密切觀察,及時處理,以免引起嚴重後果。